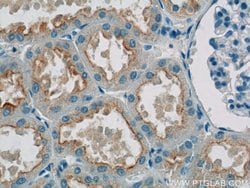
SNAP29 Rabbit anti-Human, Mouse, Rat, Polyclonal, Proteintech:Antibodies:Primary

missing translation for 'onlineSavingsMsg'
Learn More
Learn More
SNAP29 Rabbit anti-Human, Mouse, Rat, Polyclonal, Proteintech
Rabbit Polyclonal Antibody
£135.00 - £349.00
Specifications
| Antigen | SNAP29 |
|---|---|
| Concentration | 0.13 mg/mL |
| Applications | Western Blot, Immunofluorescence, Immunohistochemistry (Paraffin), Immunoprecipitation, Immunocytochemistry |
| Classification | Polyclonal |
| Conjugate | Unconjugated |
| Product Code | Brand | Quantity | Price | Quantity & Availability | |||||
|---|---|---|---|---|---|---|---|---|---|
| Product Code | Brand | Quantity | Price | Quantity & Availability | |||||
|
16830574
|
Proteintech
12704-1-AP-20UL |
20 μL |
£135.00
20µL |
Please sign in to purchase this item. Need a web account? Register with us today! | |||||
|
16820574
|
Proteintech
12704-1-AP-150UL |
150 μL |
£349.00
150µL |
Please sign in to purchase this item. Need a web account? Register with us today! | |||||
Description
This gene, a member of the SNAP25 gene family, encodes a protein involved in multiple membrane trafficking steps. Two other members of this gene family, SNAP23 and SNAP25, encode proteins that bind a syntaxin protein and mediate synaptic vesicle membrane docking and fusion to the plasma membrane. The protein encoded by this gene binds tightly to multiple syntaxins and is localized to intracellular membrane structures rather than to the plasma membrane. While the protein is mostly membrane-bound, a significant fraction of it is found free in the cytoplasm. Use of multiple polyadenylation sites has been noted for this gene.Specifications
| SNAP29 | |
| Western Blot, Immunofluorescence, Immunohistochemistry (Paraffin), Immunoprecipitation, Immunocytochemistry | |
| Unconjugated | |
| Rabbit | |
| Rat, Human, Mouse | |
| O95721, Q9ERB0, Q9Z2P6 | |
| 116500, 67474, 9342 | |
| SNAP29 Fusion Protein Ag3382 | |
| Primary | |
| -20°C | |
| SNAP29 |
| 0.13 mg/mL | |
| Polyclonal | |
| Liquid | |
| RUO | |
| PBS with 50% glycerol and 0.1% sodium azide; pH 7.3 | |
| CEDNIK, SNAP 29, SNAP29 | |
| SNAP29 | |
| IgG | |
| Antigen Affinity Chromatography | |
| Antibody |
Spot an opportunity for improvement?Share a Content Correction
Product Content Correction
Your input is important to us. Please complete this form to provide feedback related to the content on this product.
Product Title